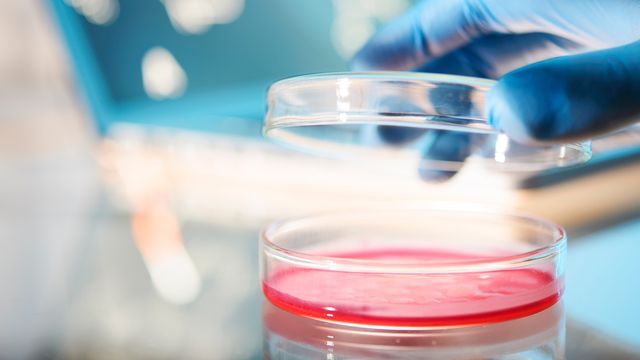

Latest How To Guides

How To Guide
Ensure High-Quality Nucleic Acids Analysis From FFPE Samples
This guide describes a streamlined approach for safely obtaining high-quality nucleic acids from FFPE samples, ensuring their integrity for NGS and other molecular applications.

How To Guide
Your Comprehensive Guide to Tools for Immuno-Oncology Research
In this guidebook, you will discover educational resources and solutions for a number of immuno-oncology research approaches, including checkpoint inhibition, CAR T cell therapy, and cancer vaccine research.

How To Guide
Precision Chemistry for Particles and Surfaces
This handbook highlights innovative technologies designed to increase analyte recovery, sensitivity and reproducibility by minimizing analyte-surface interactions that can lead to sample loss.
How To Guide
Five Fundamental Tips for Cell Harvesting
This guide presents important tips for cell harvesting that can help researchers to boost cell culture research.

How To Guide
Upscaling Organoid Research for Sharper Biological Insights
This guide explores current research challenges and highlights the latest innovative solutions to enhance drug discovery and organoid research.

How To Guide
A Guide to Cell Signaling in Cancer Development and Progression
This guide highlights some of the key pathways that are commonly dysregulated in cancer. It also explores how dysregulation can lead to pathogenesis with examples across a broad range of cell and tissue types.

How To Guide
Mitigate Risks in Your Cryotank Storage
This guide highlights how lab monitoring systems can help mitigate cryotank usage risk. It outlines protective measures to keep lab members and samples safe.

How To Guide
How To Detect and Avoid Cell Culture Contamination
In this guide, we take a look at how cell culture contamination can be avoided and some of the key ways it can be detected.

How To Guide
Reveal More With Accurate and Scalable Long-Read Sequencing
Long-read sequencing enables the accurate identification and characterization of complex genomic features. It outperforms its short-read alternatives in de novo assembly, mapping, and variant calling applications.

How To Guide
An Introduction to the Miniaturization and Automation of NGS Library Preparation Workflows
Download this Guide to explore how NGS can benefit from the miniaturization and automation of library preparation workflows.
Advertisement